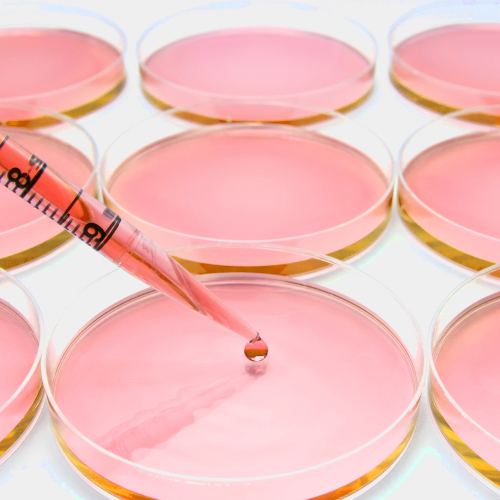

Serana Growth Additives
Serana offers a variety of supplements for effective cell culture. Our products assure superior quality and exceptional performance for your applications.

Serana Cell Detachment
Cell detachment of adherently growing cells is a key step in any culture activity using adherent cells and tissues. Serana‘s offering encompasses traditional trypsinization-based products, as well as more gentle cell detachment and dissociation products such as Accutase™ and Papain-based solutions.

Serana Purified Water Products
Purified water is water that has been mechanically filtered and processed to remove impurities. It has different grades of purity depending on the laboratory .

Serana Buffers
Cell and tissue culture buffers are an energy source. They also keep ideal osmotic pressure present and maintain proper pH levels. Used predominately in biomolecular research, the dry and liquid substances have a balanced inorganic salt composition. Lower concentration options permit equilibration with air in a closed system, while higher salt concentration options keep gaseous phases in equilibrium. Cell growth is optimal when plated in a nutritional medium that has been buffered.

Serana Transfection and Antibiotics
Antibiotics help to solve contamination issues and can attack bacterial structures in the cell. It is a common solution to use antibiotics in cell culture, such as penicillin, streptomycin, gentamicin or amphotericin as media supplements to reduce infection rates. The main reason for using antibiotics in cell culture is to kill bacteria or inhibit their proliferation. Serana has a complete set of antibiotics and transfection products to do just that.
